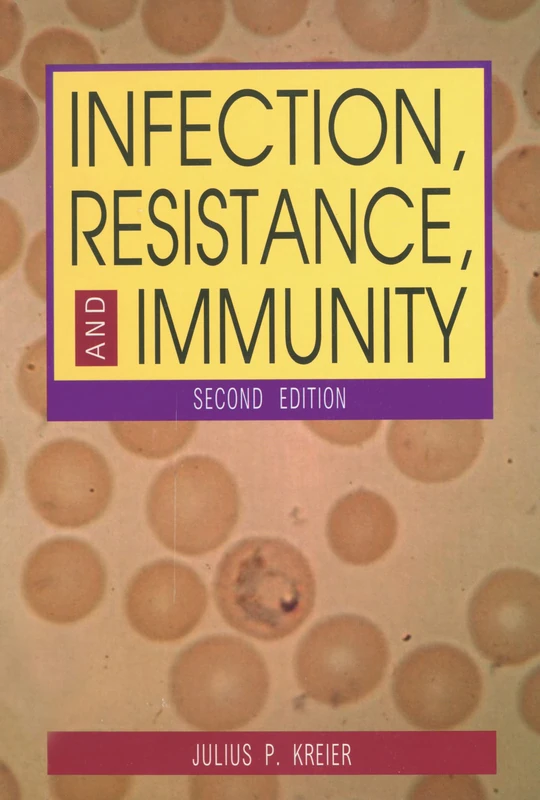
Infection, Resistance, and Immunity, Second Edition

We can't find the internet
Attempting to reconnect
Something went wrong!
Hang in there while we get back on track

£39.74
Oxford University Press Infection & Immunity
Price data last checked 110 day(s) ago - refreshing...
We'll watch every seller, every day. One email when your price arrives.
This is the usual price. Wait for it to drop, or tell us your number.
£40 today · usual range £0–£0 · best ever £35
NEW HERE?
Amazon shows you one price. We show you all of them.
Tosheroon watches Amazon prices so you don't have to. Every product on Amazon has a price history — we make it visible. Set the price you'd actually pay, and we'll email you the second it gets there. No app, no account, one email.
WHAT'S ON THIS PAGE
when this has been cheap or pricey
where the price is heading next
all-time high & low, recent range
name your number, we'll email you
Price History & Forecast
Grey patches = out of stock. Cheaper = lower on the chart. Hover for exact prices.
Last 621 days • 621 data points (No recent data available)
Price Distribution
Price distribution over 621 days • 5 price ranges
Price Analysis
Most common range: £43-46 (336 days, 54.1%)
Price range: £35 - £49
Price levels: 5 price ranges over 621 days
Description
Key Features
Infection & Immunity
Product type: ABIS BOOK
Brand: OUP Oxford
Product Specifications
- Brand
- Oxford University Press
- Format
- paperback
- ASIN
- 0199609500
- Domain
- Amazon UK
- Release Date
- 24 January 2013
- Listed Since
- 23 May 2012
Barcode
No barcode data available
Similar Products You Might Like

Infection and Immunity (Lifelines Series)
CRC Press

Sex Hormones and Immunity to Infection
Springer

Molecular Aspects of Infectious Diseases (Immunology and Immune System Disorders)

Control of Innate and Adaptive Immune Responses during Infectious Diseases
Springer

Bacterial Activation of Type I Interferons
Springer

Mims' Pathogenesis of Infectious Disease
Academic Press

Clinical Immunology 2/e
Oxford University Press

Sex Hormones and Immunity to Infection
Springer

Immunology and Evolution of Infectious Disease
Princeton University Press

Innate Immunity of Plants, Animals and Humans: 21 (Nucleic Acids and Molecular Biology, 21)
Springer
Infection, Resistance, and Immunity, Second Edition
Routledge

Mouse Models of Innate Immunity: Methods and Protocols: 1031 (Methods in Molecular Biology, 1031)
Humana

Current Topics in Innate Immunity II: 946 (Advances in Experimental Medicine and Biology, 946)
Springer

Encyclopedia of Immunology
Academic Press

Basic Immunology: Functions and Disorders of the Immune System
Elsevier

Springer - Dynamics of Immune Activation in Viral Diseases
Springer

Current Topics in Innate Immunity: 598 (Advances in Experimental Medicine and Biology, 598)
Springer

Roitt's Essential Immunology, 13th Edition (Essentials)
Wiley-Blackwell

Microbial Subversion of Immunity: Current Topics
Caister Academic Press Limited

The Paradox of the Immune System: Protection, Chronic Inflammation, Autoimmune Disease, Cancer, and Pandemics (Developments in Immunology)
Academic Press

Immunology Methods Manual CD-ROM (Immunology Methods Manual, Four-Volume Set with CD-ROM)
Academic Press

New Immunology Research Developments

Theoretical Immunology, Part Two: The Proceedings of the Theoretical Immunology Workshop, Held June, 1987 in Santa FE, New Mexico: 2
CRC Press

Immunology of Infection (Volume 25) (Methods in Microbiology, Volume 25)
Academic Press